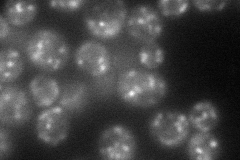
YKR030W
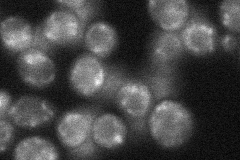
YKR030W
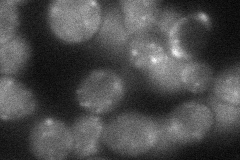
YKR030W
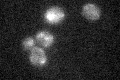
YKR030W
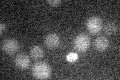
YKR030W

View description
Golgi membrane protein of unknown function, interacts with Gea1p and Gea2p; required for localization of Gea2p; computational analysis suggests a possible role in either cell wall synthesis or protein-vacuolar targeting
Localization:
Intensity:
Fold change:
Significance:
-
C’ GFP library in SD

below threshold16.38 -
N' NOP1pr-GFP in SD
punctate73.4936 -
N' TEF2pr-mCherry in SD

ER,punctate116.253 -
N' NATIVEpr-GFP in SD
punctate35.7964 -
N' TEF2pr-VC and Cyto-VN in SD
punctate38.3864 -
C’ GFP library in SD+DTT

cytosol14.740.89No -
C’ GFP library in SD+H2O2
cytosol15.520.94No -
C’ GFP library in Starvation Media
cytosol14.820.9No -
C’ GFP library on the background of Pup2-DaMP

below threshold -
C’ GFP library on the background of CCT mutant

below threshold15.89020.969687No
